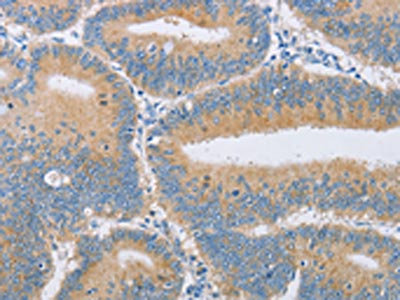

CENPE Antibody
-
中文名稱:CENPE兔多克隆抗體
-
貨號:CSB-PA963031
-
規格:¥1100
-
圖片:
-
The image on the left is immunohistochemistry of paraffin-embedded Human gastic cancer tissue using CSB-PA963031(CENPE Antibody) at dilution 1/50, on the right is treated with synthetic peptide. (Original magnification: ×200)
-
The image on the left is immunohistochemistry of paraffin-embedded Human colon cancer tissue using CSB-PA963031(CENPE Antibody) at dilution 1/50, on the right is treated with synthetic peptide. (Original magnification: ×200)
-
-
其他:
產品詳情
-
Uniprot No.:
-
基因名:CENPE
-
別名:CENPECentromere-associated protein E antibody; Centromere protein E antibody; CENP-E antibody; Kinesin-7 antibody; Kinesin-related protein CENPE antibody
-
宿主:Rabbit
-
反應種屬:Human,Mouse
-
免疫原:Synthetic peptide of Human CENPE
-
免疫原種屬:Homo sapiens (Human)
-
標記方式:Non-conjugated
-
抗體亞型:IgG
-
純化方式:Antigen affinity purification
-
濃度:It differs from different batches. Please contact us to confirm it.
-
保存緩沖液:-20°C, pH7.4 PBS, 0.05% NaN3, 40% Glycerol
-
產品提供形式:Liquid
-
應用范圍:ELISA,IHC
-
推薦稀釋比:
Application Recommended Dilution ELISA 1:1000-1:5000 IHC 1:50-1:200 -
Protocols:
-
儲存條件:Upon receipt, store at -20°C or -80°C. Avoid repeated freeze.
-
貨期:Basically, we can dispatch the products out in 1-3 working days after receiving your orders. Delivery time maybe differs from different purchasing way or location, please kindly consult your local distributors for specific delivery time.
-
用途:For Research Use Only. Not for use in diagnostic or therapeutic procedures.
相關產品
靶點詳情
-
功能:Microtubule plus-end-directed kinetochore motor which plays an important role in chromosome congression, microtubule-kinetochore conjugation and spindle assembly checkpoint activation. Drives chromosome congression (alignment of chromosomes at the spindle equator resulting in the formation of the metaphase plate) by mediating the lateral sliding of polar chromosomes along spindle microtubules towards the spindle equator and by aiding the establishment and maintenance of connections between kinetochores and spindle microtubules. The transport of pole-proximal chromosomes towards the spindle equator is favored by microtubule tracks that are detyrosinated. Acts as a processive bi-directional tracker of dynamic microtubule tips; after chromosomes have congressed, continues to play an active role at kinetochores, enhancing their links with dynamic microtubule ends. Suppresses chromosome congression in NDC80-depleted cells and contributes positively to congression only when microtubules are stabilized. Plays an important role in the formation of stable attachments between kinetochores and spindle microtubules The stabilization of kinetochore-microtubule attachment also requires CENPE-dependent localization of other proteins to the kinetochore including BUB1B, MAD1 and MAD2. Plays a role in spindle assembly checkpoint activation (SAC) via its interaction with BUB1B resulting in the activation of its kinase activity, which is important for activating SAC. Necessary for the mitotic checkpoint signal at individual kinetochores to prevent aneuploidy due to single chromosome loss.
-
基因功能參考文獻:
- SUMOylated NKAP is essential for chromosome alignment by anchoring CENP-E to kinetochores PMID: 27694884
- CENP-E motor activity appears to play important roles in the organization of midbody proteins to complete cytokinetic abscission. PMID: 27835888
- Data indicate that three genes, KIF14, NCAPG and CENPE that were upregulated in Pediatric high-grade gliomas (pHGGs) and were direct miR-137 or miR-6500-3p targets. PMID: 26933822
- CENPE was regulated by the co-binding of LSD1 and AR to its promoter, which was associated with loss of RB1 in CRPC. PMID: 28916652
- these results support a novel function of XAB2 in mitotic cell cycle regulation, which is partially mediated by transcription regulation on CENPE. PMID: 27735937
- CTCF helps recruit CENP-E to the centromere during mitosis and that it may do so through a structure stabilized by the CTCF/CENP-E complex. PMID: 26321640
- Chromokinesin Kid and kinetochore kinesin CENP-E differentially support chromosome congression without end-on attachment to microtubules. PMID: 25743205
- CENP-Q - a subunit of the CENP-O complex (comprising CENP-O, CENP-P, CENP-Q and CENP-U) that targets polo-like kinase (Plk1) to kinetochores - is also required for the recruitment of CENP-E to kinetochores. PMID: 25395579
- CENP-E-driven chromosome congression is guided by microtubule detyrosination. PMID: 25908662
- CENP-E expression is highest in basal-like subtype among breast cancer patients. PMID: 24928852
- An unexpected role of CENP-E elongated stalk in ensuring stability of kinetochore-microtubule attachments during chromosome congression and segregation. PMID: 24920822
- dynein and CENP-E at kinetochores drive congression of peripheral polar chromosomes by preventing arm-ejection forces mediated by chromokinesins from working in the wrong direction. PMID: 25383660
- Mutations in CENPE define a novel kinetochore-centromeric mechanism for microcephalic primordial dwarfism. PMID: 24748105
- A CENP-E mediated wall-tethering event and a MCAK-mediated wall-removing event show that human chromosome-microtubule attachment is achieved through a set of deterministic sequential events rather than stochastic direct capture of microtubule ends. PMID: 23891108
- The changes in ATP binding affinity and conformational deviations in human CENP-E motor domain, were studied. PMID: 23740391
- Kinetochore kinesin CENP-E is a processive bi-directional tracker of dynamic microtubule tips. PMID: 23955301
- In this study we investigated the pathogenic effect of 132 nsSNPs reported in CENP-E using computational platform. PMID: 22974711
- Evolutionarily conserved protein ERH controls CENP-E mRNA splicing and is required for the survival of KRAS mutant cancer cells. PMID: 23236152
- the unusually slow CENP-E microtubule association step favors CENP-E binding of stable microtubules over dynamic ones, a mechanism that would bias CENP-E binding to kinetochore fibers. PMID: 22637578
- Data show that CENP-E-mediated traction forces on misaligned chromosomes are responsible for the irreversible loss of spindle-pole integrity in CLASP1/2-depleted cells. PMID: 22307330
- SKAP cooperates with CENP-E to orchestrate dynamic kinetochore-microtubule interaction for faithful chromosome segregation. PMID: 22110139
- MPS1 is required by cells to arrest in mitosis in response to spindle defects and kinetochore defects resulting from the loss of the kinesin-like protein. PMID: 12686615
- Aurora B allowed chromosome alignment in CENP-E-compromised cells; implied that by destabilizing pole proximal syntelic attachments, Aurora B cooperates with CENP-E to mediate congression of mono-oriented polar chromosomes PMID: 20354862
- An Aurora/PP1 phosphorylation switch modulates CENP-E motor activity as a feature of chromosome congression from poles and localized PP1 delivery by CENP-E to the outer kinetochore is necessary for stable microtubule capture by those chromosomes. PMID: 20691903
- CENP-E expression was reduced in human hepatocellular carcinoma PMID: 20021663
- CENP-E integrates two critical functions that are important for accurate chromosome movement and spindle architecture: one relying directly on its motor activity, and the other involving the targeting of key microtubule regulators to kinetochores. PMID: 19733075
- x-ray crystallographic analysis of the motor domain of human kinetochore-associated protein CENP-E using an automated crystallization procedure PMID: 15159587
- Depletion of CENP-E leads to chromosomes missegregation and cell death during mitotic delay. PMID: 15181147
- crystal structure reveals that the CENP-E linker region is in a "docked" position identical to that in the human plus-end directed conventional kinesin PMID: 15236970
- Results support a plus end motion for CENP-E, based on a cryoelectron microscopy density map of the complex to 17 A resolution, which is consistent with features of the crystallographic structure. PMID: 16926026
- HsNUF2 and CENP-E are required for organization of stable microtubule-kinetochore attachment that is essential for faithful chromosome segregation in mitosis PMID: 17535814
- Global inhibition of SUMOylation caused a prometaphase arrest due to defects in targeting the microtubule motor protein CENP-E to kinetochores. PMID: 18374647
- Chromosome congression in HSET + hNuf2 co-depleted cells required the plus-end directed motor CENP-E , which has been implicated in the gliding of mono-oriented kinetochores alongside adjacent K-fibres. PMID: 19525938
- Data show that the kinetochore localization of PinX1 is dependent on Hec1 and CENP-E. PMID: 19553660
- Studies strongly suggest that chromosome congression defects as the result of KIF18A depletion is at least in part mediated through destabilizing kinetochore CENP-E. PMID: 19625775
顯示更多
收起更多
-
相關疾病:Microcephaly 13, primary, autosomal recessive (MCPH13)
-
亞細胞定位:Chromosome, centromere, kinetochore. Cytoplasm, cytoskeleton, spindle. Chromosome, centromere.
-
蛋白家族:TRAFAC class myosin-kinesin ATPase superfamily, Kinesin family
-
數據庫鏈接:
Most popular with customers
-
YWHAB Recombinant Monoclonal Antibody
Applications: ELISA, WB, IHC, IF, FC
Species Reactivity: Human, Mouse, Rat
-
Phospho-YAP1 (S127) Recombinant Monoclonal Antibody
Applications: ELISA, WB, IHC
Species Reactivity: Human
-
-
-
-
-
-